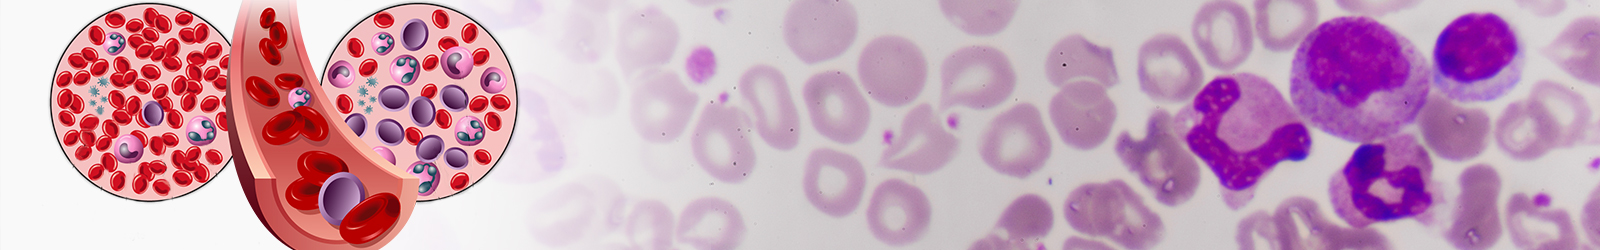
lymphomas in chennai

Lymphoma/Leukemia
Cancer can affect not only any part of the body but also the blood. There are two types of blood cancer - lymphoma and leukemia. Both typically affect the white blood cells. The main difference is that lymphomas affect the lymph nodes while leukemia affects the bone marrow and blood.
These two types of cancer have similarities but their symptoms, causes and origins, and treatment are different.
Leukemia
When the bone marrow produces too many abnormal white blood cells it causes Leukemia.
Lymphoma
Lymphoma affects the lymph nodes and lymphocytes and starts in the immune system.
Hodgkin lymphoma and Non-Hodgkin lymphoma are the two types of lymphoma.
Symptoms
Leukemia is often a chronic or slowly progressing condition. Symptoms may not be immediately evident.
Symptoms of Leukemia include:
- Enlarged lymph nodes
- Difficulty in breathing
- Tiredness
- Fever
- Bleeding from gums or nose
- Feeling dizzy, or weak
- Infections that do not heal
- Easily bruised skin
- Loss of appetite
- Swelling in the abdomen
- Weight loss
- Spots in the skin that are rust-colored
- Bone pain
- Excessive sweating
Symptoms of Lymphoma
Depending on the type, the symptoms of lymphoma vary. Hodgkin lymphoma symptoms can include:
- A lump usually in the groin, armpit or neck
- Fever
- Weight loss
- Excessive sweating
- Coughing or trouble breathing
- Severe itching
Symptoms of Non-Hodgkin Lymphoma include:
- A swollen abdomen
- Feeling full
- Enlarged lymph nodes
- Fever
- Weight loss
- Sweating and chills
- Fatigue
The highlighted symptoms, are called B symptoms and indicate worse prognosis in these patients.
Causes and origins
Problems with the body’s white blood cells lead to both Leukemia and Lymphoma.
Leukemia occurs when the bone marrow produces too many white blood cells that do not die off in a normal cycle. They eventually push out other healthy blood cells.
Leukemia may also start in the lymph nodes. To help the immune system fight infections lymph nodes are responsible. Similarly, lymphoma typically starts in the lymphatic tissues or lymph nodes.
Risk Factors
Lymphoma and leukemia have different risk factors.
While adults most often have chronic leukemia children are more likely to be diagnosed with acute leukemia.
Some of the risk factors include:
- Genetic disorders
- Family history
- Exposure to certain types of chemicals
- Chemotherapy or radiation
- Smoking
Lymphoma can occur at any age. It is between the ages of 15 and 40 or after 50 that Hodgkin’s lymphoma typically occurs. Non-Hodgkin’s lymphoma is more common among older adults.
Hodgkin’s lymphoma risk factors include:
- Family history
- Weakened immune system
- Epstein-Barr virus (EBV) infection
- HIV infection
Non-Hodgkin’s lymphoma risk factors include:
- Weakened immune system
- Exposure to some chemicals
- Chronic Helicobacter pylori infection
- Previous radiation or chemotherapy
- Autoimmune diseases
The types of Leukemia include:
- Acute lymphocytic leukemia
- Chronic lymphocytic leukemia
- Acute myeloid leukemia
- Chronic myeloid leukemia
Diagnosis
Lymphoma and Leukemia are diagnosed differently but both require a complete medical history and physical examination.
To look for abnormal blood counts, the doctor will do blood tests to diagnosis abnormalities. A bone marrow biopsy may also be performed, which does not usually require a hospital stay. Before taking a sample the doctor will apply local anaesthesia. In certain cases, a doctor may order imaging tests or chromosome testing.
A biopsy from the tissue that appears to be affected will be taken if a doctor suspects that a person has lymphoma. A local or general anaesthesia is required for this procedure.

Treatment
There are different treatments for each type of leukemia or lymphoma. The doctor may use:
- Chemotherapy
- Stem cell transplant
- Targeted therapy
- Biological therapy
- Radiation therapy
Treatment for Hodgkin’s and non-Hodgkin's lymphoma can include:
- Radiation therapy
- Chemotherapy
- Drugs to prevent the growth of abnormal cells
- Targeted therapy
- Immunotherapy
- Stem cell transplant
- In rare cases, surgery is recommended
1
Authored By Dr. M. Banupriya
MBBS, MDRT, FIAMS, Ph.D, CCEPC (Palliative care), Consultant Oncologist